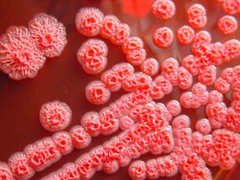
Post cover 105821

Con trai đạo diễn Trần Lực: Nhận học bổng quốc...
World Cup 2026 có thể thành giải đấu gây ô...
16 chuyến bay bị ảnh hưởng bởi UAV, Cảng vụ...
Sự nghiệp rực rỡ của mỹ nhân đóng thái tử...
World Cup 2026 chờ Messi, Mbappe phá kỷ lục
Lộ diện 3 doanh nghiệp được Hà Nội chốt thực...
Triệt phá xưởng sản xuất hơn 23.000 đôi dép giả...
Bahrain tuyên bố đánh chặn 3 tên lửa của Iran
Miền Bắc đón không khí lạnh cuối mùa, trời chuyển...
Vinpearl Legendlux – thương hiệu khách sạn siêu sang tôn...
Bí ẩn chiều cao ngọn Everest và câu chuyện cộng...
Con trai đạo diễn Trần Lực: Nhận học bổng quốc...
World Cup 2026 có thể thành giải đấu gây ô...
16 chuyến bay bị ảnh hưởng bởi UAV, Cảng vụ...
Sự nghiệp rực rỡ của mỹ nhân đóng thái tử...
World Cup 2026 chờ Messi, Mbappe phá kỷ lục
Lộ diện 3 doanh nghiệp được Hà Nội chốt thực...
Triệt phá xưởng sản xuất hơn 23.000 đôi dép giả...
Bahrain tuyên bố đánh chặn 3 tên lửa của Iran
Miền Bắc đón không khí lạnh cuối mùa, trời chuyển...
Vinpearl Legendlux – thương hiệu khách sạn siêu sang tôn...
Bí ẩn chiều cao ngọn Everest và câu chuyện cộng...
Tin mới

Bệnh Whitmore không lây từ người sang người
Hiện chưa có bằng chứng khoa học thuyết phục nào về sự lây bệnh Whitmore giữa người với người hoặc từ động vật sang người qua con đường không khí.
24/11/2019 16:00:57
Bệnh Whitmore nguy hiểm, nhưng hoàn toàn phòng tránh được
Sự việc 2 chị em ruột trong một gia đình ở Sóc Sơn (Hà Nội) liên tiếp tử vong vì mắc bệnh Whitmore đã khiến cho nhiều gia đình hoang mang, lo lắng. Tuy nhiên, các chuyên gia y tế cho rằng, căn bệnh này hoàn toàn có thể phòng tránh được nếu người dân tuân thủ những khuyến cáo của ngành y tế.
21/11/2019 16:34:46

Vi khuẩn Whitmore và vi khuẩn "ăn thịt người" có phải là một?
Thông tin vi khuẩn “ăn thịt người” đang khiến cho người dân hoang mang. Tuy nhiên, theo các chuyên gia, gán cho con vi khuẩn Whitmore là vi khuẩn “ăn thịt người” (flesh eating bacteria) là không chính xác.
19/09/2019 23:27:36

4 bệnh nhân BV Bạch Mai tử vong do whitmore, những dấu hiệu cần biết
Whitmore hiện chưa có vắc xin phòng bệnh, việc chẩn đoán gặp nhiều khó khăn do các triệu chứng dễ dầm lẫn với nhiều bệnh khác.
11/09/2019 23:17:40

Bệnh Whitmore đột ngột tấn công nhiều người miền Bắc
12 bệnh nhân Whitmore điều trị ở Trung tâm Bệnh Nhiệt đới, Bệnh viện Bạch Mai, Hà Nội, trong tháng 8, trong đó 4 người đã tử vong.
10/09/2019 22:54:20
Bài đọc nhiều

TP.HCM sẽ xây dựng các khu dân cư xã hội chủ nghĩa, thí điểm 5 phường xã

Đô thị đáng sống Vinhomes Sài Gòn Park hút mạnh khách ở thực trước ngày “bung” giỏ hàng 6/6

Agribank được vinh danh thành tựu vì Việt Nam số 2026

Mỹ trục xuất người nhập cư: Chuyến bay phá vỡ giấc mơ của những người nhập cư Mỹ

'Wreck-It Ralph 2' - chuyến phiêu lưu hài hước vào thế giới Internet


